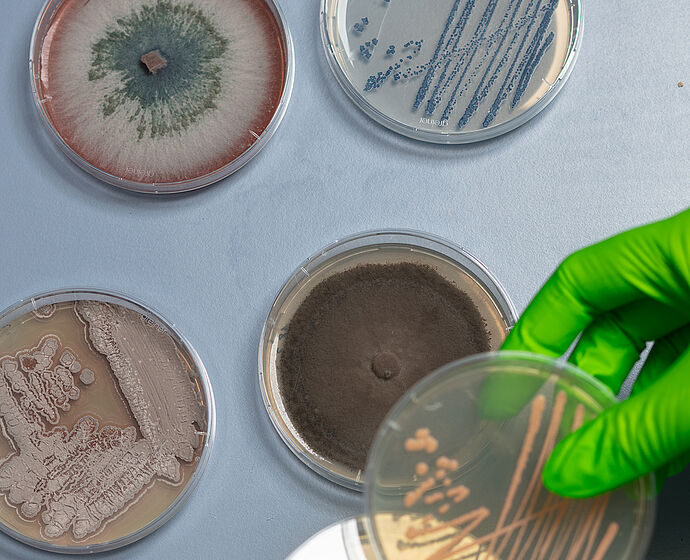
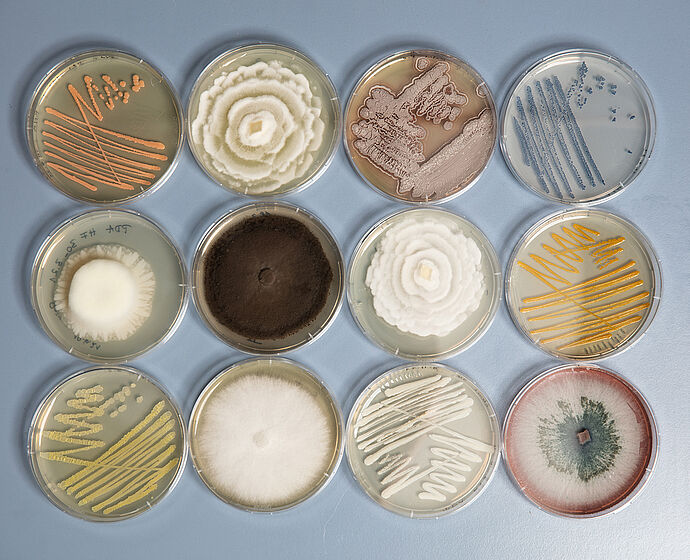

30 Jahre FH Erfurt - Zusammen an Pflanzen forschen
Wir laden Sie zu einem Einblick in die Arbeiten an der Forschungsstelle für gartenbauliche Kulturpflanzen (FGK) in Kühnhausen ein. Legen Sie selbst Hand an und bestäuben Sie Blüten, extrahieren Sie Chlorophyll, entlocken den Bakterien ihre Geheimnisse und spielen mit Farben und Mustern. Erfahren Sie an vier verschiedenen Stationen in unseren Laboren und Gewächshäusern mehr zu:
- "So vielfältig ist Züchtungsforschung"
- "So bunt ist Epigenetik"
- "Bakterien und Pilze, die unterirdischen Helfer der Pflanzen"
- "Auf den Spuren der Wurzelentwicklung"
Der Besuch der vier Stationen beginnt jeweils zu folgenden Zeiten an der FGK: 09:00, 11:30 und 15:00 Uhr
Wenn Sie alle Stationen besuchen wollen, haben Sie je Station 30 Minuten zur Verfügung. Sollte Sie ein Thema besonders interessieren, haben Sie darüber hinaus die Möglichkeit, nach den 30 Minuten bei der Station zu bleiben, und selbst mitzumachen.